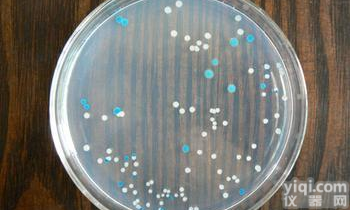
胰酪胨大豆<em>琼脂</em>（<em>卵磷脂</em>+<em>吐温</em> 80+青霉素酶）

CAS:/TTC卵磷脂吐温80营养琼脂/三苯四唑卵磷脂吐温80营养琼脂/氯化三苯四氮卵磷脂吐温80营养琼脂/红四氮唑卵磷脂吐温80营养琼脂/三苯基氯化四氮唑卵磷脂吐温80营养琼脂/
- 型号:P0355
- 产地:其它
- 供应商:上海博华生物科技有限公司
- 供应商报价:电议
- 标签:CAS:/TTC卵磷脂吐温80营养琼脂/三苯四唑卵磷脂吐温80营养琼脂/氯化三苯四氮卵磷脂吐温80营养琼脂/红四氮唑卵磷脂吐温80营养琼脂/三苯基氯化四氮唑卵磷脂吐温80营养琼脂/,生物试剂,生化试剂,供应CAS:/TTC卵磷脂吐温80营养琼脂/三苯四唑卵磷脂吐温80营养琼脂/氯化三苯四氮卵磷脂吐温80营养琼脂/红四氮唑卵磷脂吐温80营养琼脂/三苯基氯化四氮唑卵磷脂吐温80营养琼脂/,上海博华生物科技有限公司
产品信息
CAS:/TTC卵磷脂吐温80营养琼脂/三苯四唑卵磷脂吐温80营养琼脂/氯化三苯四氮卵磷脂吐温80营养琼脂/红四氮唑卵磷脂吐温80营养琼脂/三苯基氯化四氮唑卵磷脂吐温80营养琼脂/TTC Lecithin Tween 80 Nutrient Agar更多详情,欢迎来电咨询!
关于CAS:/TTC卵磷脂吐温80营养琼脂/三苯四唑卵磷脂吐温80营养琼脂/氯化三苯四氮卵磷脂吐温80营养琼脂/红四氮唑卵磷脂吐温80营养琼脂/三苯基氯化四氮唑卵磷脂吐温80营养琼脂/TTC Lecithin Tween 80 Nutrient Agar更多详情,请致电咨询!产品名称:CAS:/TTC卵磷脂吐温80营养琼脂/三苯四唑卵磷脂吐温80营养琼脂/氯化三苯四氮卵磷脂吐温80营养琼脂/红四氮唑卵磷脂吐温80营养琼脂/三苯基氯化四氮唑卵磷脂吐温80营养琼脂/TTC Lecithin Tween 80 Nutrient Agar
货号:P0355
规格:用于化妆品中细菌总数测定
包装:250克
保存条件:RT
CAS:/TTC卵磷脂吐温80营养琼脂/三苯四唑卵磷脂吐温80营养琼脂/氯化三苯四氮卵磷脂吐温80营养琼脂/红四氮唑卵磷脂吐温80营养琼脂/三苯基氯化四氮唑卵磷脂吐温80营养琼脂/TTC Lecithin Tween 80 Nutrient Agar相关产品>>>>
P0613 CAS:/蛋白胨水(色氨酸肉汤)发酵管
A0169 CAS:59-92-7/L-多巴/3-羟基-L-酪氨酸/左旋多巴/L-β-(3,4-二羟基苯)丙氨酸/L-3-(3,4-二羟基苯)丙氨酸/左多巴/3-(3,4-二羟基苯)-L-丙氨酸/β-[3,4-二羟苯基]L-初油氨基酸/L-Dopa
Q1707 CAS:3682-35-7/2,4,6-三吡啶基三嗪/2,4,6-三(2-吡啶基)-1,3,5-三嗪/2,4,6-三(2-吡啶基)均三嗪/2,4,6-三(2-吡啶基)三嗪/2,4,6-反式2-吡啶基三嗪/TPTZ
P0613 CAS:/蛋白胨水(色氨酸肉汤)发酵管
A0303 CAS:68-95-1/N-乙酰-L-脯氨酸/N-Acetyl-L-Proline
Q0044 CAS:305-72-6/α-酮戊二酸钠/2-酮戊二酸钠/2-氧代戊二酸钠/α-氧代戊二酸二钠/2-氧代-1,5-戊二酸二钠盐/α-酮基戊二酸二钠盐/α-Ketoglutaric acid disodium salt
Q0706 CAS:106-32-1/正辛酸乙酯/辛酸乙酯/羊脂酸乙酯/亚羊脂酸乙酯/Ethyl octanoate
S0086 CAS:1064-48-8/氨基黑10B/萘酚蓝黑/水牛黑NBR/酸性黑1/苯胺蓝黑/酸性黑10B/酸性蓝黑10B/酸性青光蓝10B/4-氨基-5-羟基-3-(对硝基苯偶氮)-6-(苯偶氮)-2,7-萘二磺酸二钠盐/萘蓝黑/对硝基苯偶氮-3,6-二磺酸-1-氨基-8-萘酚-7-偶氮苯钠盐/Amino black 10B
A0143 CAS:60-32-2/6-氨基正己酸/6-氨基己酸/氨基己酸/氨己酸/抗血纤溶酸/ε氨基已酸/6-Aminocaproic acid/EACA
B0007 CAS:1120-02-1/十八烷基三甲基溴化铵/硬脂基三甲基溴化铵/溴化正硬脂基三甲基铵/十八烷基二甲基苄基溴化铵/三甲基十八烷基溴化铵/表面活性剂1831/溴化三甲基十八烷基铵/STAB
Q1836 CAS:2594628/嵌段式聚醚F-68/聚醚/环氧丙烷与环氧乙烷的共聚物/聚氧乙烯聚氧丙烯/聚乙二醇接枝聚丙二醇/泊洛沙姆/聚醚多元醇/聚氧丙烯聚氧乙烯共聚物/Pluronic F-68
Q1758 CAS:20736-09-8/柴胡皂苷A/柴胡皂甙A/Saikosaponin A
Q0358 CAS: 552-89-6/2-硝基苯甲醛/邻硝基苯甲醛/2-Nitrobenzaldehyde
A0114 CAS:616-91-1/N-乙酰-L-半胱氨酸/蛋乙酰半胱/ N-乙酰-L-β-巯基丙氨酸/LNAC/NAC
P0172 CAS:/改良BPLS琼脂/BPLS Agar Modified
Z0057-1 CAS:123334-07-6/5-胞苷三磷酸三钠盐/5-胞嘧啶核苷三磷酸三钠盐/胞苷-5′-三磷酸三钠盐/5′-CTP,3Na
A0078 CAS:80-68-2/DL-苏氨酸/DL-α-氨基-β-羟基丁酸/(±)-2-氨基-3-羟基丁酸/DL-羟基丁氨酸/DL-异赤丝藻氨基酸/DL-Theronine
A0200 CAS:5534-95-2/五肽胃泌素/五肽促胃液素/N-[(1,1-二甲乙氧基)羰基]-β-丙氨酰-L-色氨酰-L-甲硫氨酰-L-门冬氨酰-L-苯丙酰胺/Pentagastrin
A0292 CAS:26340-89-6/L-精氨酸甲酯/L-精氨酸甲酯盐酸盐/L-Arginine methyl ester dihydrochloride
S0137-2 CAS:88-74-4/邻硝基苯胺/2-硝基苯胺/1-氨基-2-硝基苯/2-Nitroaniline
CAS:/TTC卵磷脂吐温80营养琼脂/三苯四唑卵磷脂吐温80营养琼脂/氯化三苯四氮卵磷脂吐温80营养琼脂/红四氮唑卵磷脂吐温80营养琼脂/三苯基氯化四氮唑卵磷脂吐温80营养琼脂/TTC Lecithin Tween 80 Nutrient Agar
信息声明:本产品供应信息由仪器网为您整合,供应商为(上海博华生物科技有限公司),内容包括
(CAS:/TTC卵磷脂吐温80营养琼脂/三苯四唑卵磷脂吐温80营养琼脂/氯化三苯四氮卵磷脂吐温80营养琼脂/红四氮唑卵磷脂吐温80营养琼脂/三苯基氯化四氮唑卵磷脂吐温80营养琼脂/)的品牌、型号、技术参数、详细介绍等;如果您想了解更多关于
(CAS:/TTC卵磷脂吐温80营养琼脂/三苯四唑卵磷脂吐温80营养琼脂/氯化三苯四氮卵磷脂吐温80营养琼脂/红四氮唑卵磷脂吐温80营养琼脂/三苯基氯化四氮唑卵磷脂吐温80营养琼脂/)的信息,请直接联系供应商,给供应商留言!